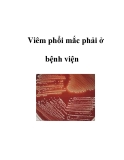

Vi khuẩn gây viêm phổi thở máy
-
Tài liệu "Hướng dẫn chẩn đoán và xử trí hồi sức tích cực: Viêm phổi liên quan đến thở máy" cung cấp cho học viên nội dung về: đại cương, nguyên nhân gây bệnh, triệu chứng lâm sàng - cận lâm sàng, chẩn đoán xác định - chẩn đoán nguyên nhân - chẩn đoán mức độ, nguyên tắc xử trí viêm phổi liên quan đến thở máy, xử trí ban đầu và vận chuyển cấp cứu, xử trí tại bệnh viện, tiên lượng và biến chứng, các phương pháp phòng bệnh. Mời các bạn cùng tham khảo!
 10p
10p  leetranhh
leetranhh
 20-05-2025
20-05-2025
 2
2
 1
1
 Download
Download
-
Bài viết trình bày đánh giá vi khuẩn và mức độ kháng kháng sinh của vi khuẩn gây bệnh trên bệnh nhân chấn thương có viêm phổi liên quan đến thở máy. Phương pháp nghiên cứu: tiến cứu mô tả cắt ngang trên 63 bệnh nhân người lớn bị chấn thương được chẩn đoán viêm phổi liên quan đến thở máy, tiến hành lấy dịch phế quản gửi tới khoa vi sinh để nuôi cấy, phân lập vi khuẩn và làm kháng sinh đồ, số liệu được mã hóa và xử lý theo các phương pháp thống kê.
 5p
5p  viormkorn
viormkorn
 06-11-2024
06-11-2024
 1
1
 1
1
 Download
Download
-
Bài viết mô tả đặc điểm căn nguyên vi khuẩn gây bệnh viêm phổi liên quan thở máy tại khoa Hồi sức tích cực – chống độc Bệnh viện Đa khoa Xanh Pôn. Thiết kế nghiên cứu: Mô tả cắt ngang, theo dõi dọc thực hiện trên 73 bệnh nhân thở máy tại khoa Hồi sức tích cực và chống độc Bệnh viện đa khoa Xanh Pôn từ tháng 8/2023 đến tháng 7/2024.
 6p
6p  viuzumaki
viuzumaki
 28-03-2025
28-03-2025
 2
2
 0
0
 Download
Download
-
Bài viết trình bày kết luận: Tại khoa HSCC, các VK gây bệnh đề kháng với các KS chủ lực từ cao đến rất cao, việc lựa chọn kháng sinh theo kinh nghiệm trong thời gian chờ đợi kết quả vi sinh là cần thiết. Hiệu quả của những công việc này phụ thuộc vào khả năng theo dõi phân bố VK và đặc điểm kháng thuốc tại từng đơn vị.
 9p
9p  vinara
vinara
 11-01-2025
11-01-2025
 7
7
 1
1
 Download
Download
-
Bài giảng Nghiên cứu đặc điểm lâm sàng, cận lâm sàng và căn nguyên vi sinh của viêm phổi liên quan thở máy tại Bệnh viện Đa khoa tỉnh Hưng Yên do Ths.BsCKII. Ngô Duy Đông biên soạn trình bày các nội dung chính sau: Mô tả đặc điểm lâm sàng, cận lâm sàng của bệnh nhân viêm phổi liên quan thở máy tại bệnh viện đa khoa tỉnh Hưng Yên; Xác định căn nguyên gây VPLQTM và đánh giá thực trạng kháng kháng sinh của các vi khuẩn gây viêm phổi liên quan thở máy. Mời các bạn cùng tham khảo để nắm nội dung chi tiết.
 32p
32p  vivelvet2711
vivelvet2711
 06-09-2021
06-09-2021
 54
54
 5
5
 Download
Download
-
Luận án Tiến sĩ Y học "Nghiên cứu căn nguyên, kết quả điều trị và xác định đường lây truyền của các vi khuẩn đa kháng thuốc gây viêm phổi liên quan đến thở máy bằng kỹ thuật giải trình tự gen thế hệ mới" trình bày các nội dung chính sau: Xác định căn nguyên và đặc tính kháng kháng sinh của các vi khuẩn gây viêm phổi liên quan thở máy tại khoa Hồi sức tích cực, bệnh viện Bệnh Nhiệt đới trung ương (7/2017 – 1/2018); Xác định nguồn lây truyền các vi khuẩn đa kháng thuốc gây viêm phổi liên quan thở máy bằng kỹ thuật giải trình tự gen thế hệ mới.
 210p
210p  vibugatti
vibugatti
 08-09-2022
08-09-2022
 28
28
 5
5
 Download
Download
-
Mục tiêu của luận án xác định đặc điểm vi khuẩn gây viêm phổi thở máy bằng kỹ thuật giải trình tự gene 16S-rRNA, có so sánh với phương pháp định danh vi khuẩn dựa vào nhuộm Gram, nuôi cấy và các phản ứng sinh hóa. Xác định gene kháng thuốc của vi khuẩn gây viêm phổi thở máy bằng kỹ thuật PCR và mối liên quan với MIC.
 27p
27p  angicungduoc6
angicungduoc6
 21-07-2020
21-07-2020
 48
48
 4
4
 Download
Download
-
Viêm phổi bệnh viện (VPBV) (hospital acquired pneumonia – HAP) là viêm phổi xảy ra sau 48 giờ nhập viên mà trước đó phổi bình thường. Viêm phổi kết hợp thở máy (VPTM) (ventilation asscociated pneumonia – VAP) là viêm phổi xảy ra sau 48-72 sau đặt nội khí quản. Những bệnh nhân cần đặt nội khí quản sau khi bị VPBV nặng thì cũng cần điều trị như VPTM Viêm phổi trong các đơn vị y tế (VPĐVYT) (health care asscociated pneumonia –HCAP) bao gồm những bệnh nhân nằm viện trong 2 ngày hay hơn trong vòng 90...
 6p
6p  nuoccam111
nuoccam111
 05-05-2011
05-05-2011
 209
209
 15
15
 Download
Download
-
Thở máy là nguyên nhân hàng đầu gây viêm phổi mắc phải ở bệnh viện. Viêm phổi mắc phải ở bệnh viện là bệnh lý viêm phổi xuất hiện sau nhập viện 48 giờ. Bao gồm cả các trường hợp viêm phổi do thầy thuốc, viêm phổi trên bệnh nhân thở máy (Các bệnh lý này không có triệu chứng khi nhập viện). Tỷ lệ tử vong do viêm phổi mắc phải ở bệnh viện rất cao: 30 – 70%. 1. Nguyên nhân gây bệnh Những vi khuẩn gây viêm phổi mắc phải ở bệnh viện thường gặp bao...
 4p
4p  alotra1209
alotra1209
 25-03-2011
25-03-2011
 136
136
 12
12
 Download
Download
CHỦ ĐỀ BẠN MUỐN TÌM